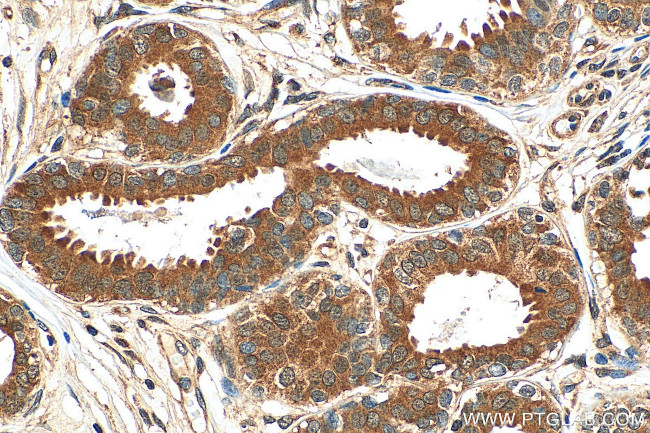
SRP54 Antibody in Immunohistochemistry (Paraffin) (IHC (P))

Search
Proteintech
SRP54 Polyclonal Antibody
{{$productOrderCtrl.translations['antibody.pdp.commerceCard.promotion.promotions']}}
{{$productOrderCtrl.translations['antibody.pdp.commerceCard.promotion.viewpromo']}}
{{$productOrderCtrl.translations['antibody.pdp.commerceCard.promotion.promocode']}}: {{promo.promoCode}} {{promo.promoTitle}} {{promo.promoDescription}}. {{$productOrderCtrl.translations['antibody.pdp.commerceCard.promotion.learnmore']}}
产品信息
11729-1-AP
种属反应
已发表种属
宿主/亚型
分类
类型
抗原
偶联物
形式
浓度
规格
纯化类型
保存液
内含物
保存条件
运输条件
产品详细信息
Immunogen sequence: DPVIIASEG VEKFKNENFE IIIVDTSGRH KQEDSLFEEM LQVANAIQPD NIVYVMDASI GQACEAQAKA FKDKVDVASV IVTKLDGHAK GGGALSAVAA TKSPIIFIGT GEHIDDFEPF KTQPFISKLL GMGDIEGLID KVNELKLDDN EALIEKLKHG QFTLRDMYEQ FQNIMKMGPF SQILGMIPGF GTDFMSKGNE QESMARLKKL MTIMDSMNDQ ELDSTDGAKV FSKQPGRIQR VARGSGVSTR DVQELLTQYT KFAQMVKKMG GIKGLFKGGD MSKNVSQSQM AKLNQQMAKM MDPRVLHHMG GMAGLQSMMR QFQQGAAGNM KGMMGFNNM (167-505 aa encoded by BC003389)
靶标信息
Binds to the signal sequence of presecretory protein when they emerge from the ribosomes and transfers them to TRAM (translocating chain-associating membrane protein).
仅用于科研。不用于诊断过程。未经明确授权不得转售。
生物信息学
蛋白别名: 54K subunit of signal recognition particle; Signal recognition particle 54 kDa protein; signal recognition particle 54kD; signal recognition particle 54kDa; Signal recognition particle subunit SRP54; unnamed protein product
基因别名: 54kDa; SCN8; SRP54
UniProt ID: (Human) P61011, (Mouse) P14576
Entrez Gene ID: (Human) 6729, (Mouse) 24067